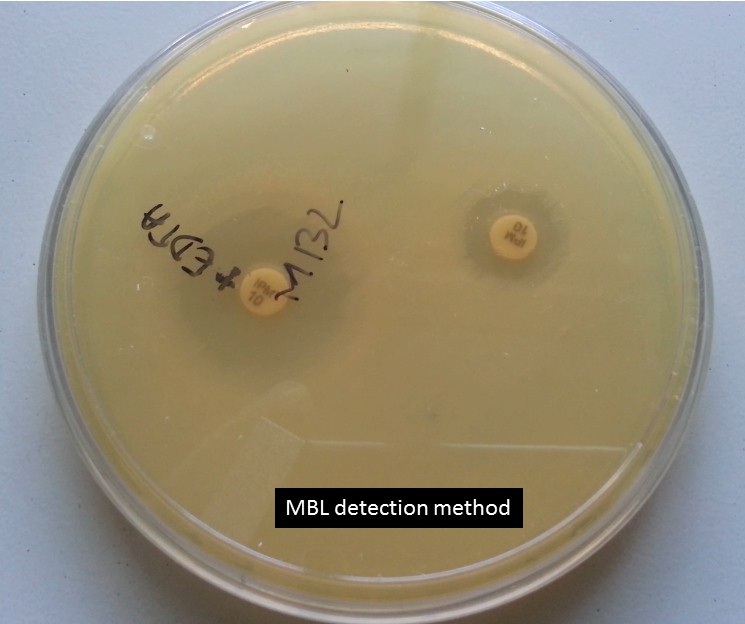
MBL detection method

MBL: Introduction, Mechanism of Action, Family and Detection Methods
Introduction of MBL
MBL stands for Metallo β- lactamase and according to Ambler, the scheme comes under class B. This class of β -lactamases is characterized by the ability to hydrolyze carbapenems and by its resistance to the commercially available β- lactamase inhibitors (clavulanic acid and tazobactam) but susceptibility to inhibition by metal ion chelators. The substrate spectrum is quite broad; in addition to the carbapenems, most of these enzymes hydrolyze cephalosporins and penicillins but lack the ability to hydrolyze aztreonam.
Mechanism of Action of MBL
The mechanism of hydrolysis is dependent on the interaction of the β- lactams with zinc ions in the active site of the enzyme, resulting in the distinctive trait of their inhibition by EDTA, a chelator of zinc ion and other divalent cations. The first MBLs detected and studied were chromosomal enzymes present in environmental and opportunistic pathogenic bacteria such as Bacillus cereus, Aeromonas spp., and S. maltophilia. MBLs mediate resistance to β- lactams by cleaving the amide bond of the β-lactam ring. They possess a distinct set of amino acids that define the finite architecture of the active site which coordinated the zinc ions. The zinc ions in turn usually coordinate two water molecules necessary for hydrolysis. The principal zinc-binding motif is histidine- X–histidine –X aspartic acid. The proposed mechanism of hydrolysis suggests that the active site orients and polarizes the β- lactam bond to facilitate nucleophilic attack by zinc-bound water/ hydroxides. The MBL mechanism of hydrolysis is complex and varies from one MBL to another. Unlike serine β -lactamases, MBLs possess a wide plastic active site groove and accordingly can accommodate most β- lactam substrates, facilitating their very broad spectrum of activity. They are also impervious to the impending effects of serine inhibitors such as Clavulanic acid and sulbactam that are often treated as poor substrates. Interestingly, none of the MBLs hydrolyze aztreonam particularly well, and it has been speculated that it could be considered a therapeutic MBL inhibitor (see the section on inhibitors). However, in studies of animals with pneumonia caused by P. aeruginosa producing VIM- 2, the infection could not be eradicated with aztreonam even when the animals were given high drug doses. MBLs are currently divided into three subclasses based on a combination of structural features, zinc affinities for the two binding sites, and hydrolysis characteristics. MBLs like all β-lactamases can be divided into those that are normally chromosomally mediated and those that are encoded by transferable genes.
MBL Families
The most common MBL families include the IMP, VIM, GIM, SIM, and SPM enzymes which are located within a variety of integron structures, where they have been incorporated as gene cassettes. When these integrons become associated with plasmids or transposons, transfer between bacteria is readily facilitated.
IMP: The first indication of mobile MBLs (IMP 1) was with the discovery of P. aeruginosa strain GN 17203 in Japan in 1988. IMP enzymes spread slowly to other countries in the Far East, were reported from Europe in 1997, and have been found in Canada and Brazil.
VIM: VIM -1 (‘Verona integron – encoded MBL’) was first isolated in Verona, Italy, in 1997. Currently, it consists of 14 members which have a wide geographic distribution in Europe, South America, and the Far East and have also been found in the United States. VIM enzymes mostly occur in P. aeruginosa, also P. putida, and very rarely, Enterobacteriaceae.
SPM: SPM -1 (‘Sao Paulo MBL’) was first isolated in the P. aeruginosa strain in Sao Paulo, Brazil.
GIM: GIM-1 (‘German imipenemase’) was isolated in Germany in 2002. It has approximately 30% homology to VIM, 43% to IMPs, and 29% to SPM.
SIM: The latest family, i.e., SIM-1 (‘Seoul imipenemase’) was isolated in Korea. Since their initial discoveries, SPM, GIM, and SIM MBLs have not spread beyond their countries of origin. However, VIM and IMP continue to be detected worldwide, with an overall trend of these two MBLs moving beyond P. aeruginosa and into the Enterobacteriaceae.
Problems Regarding Inhibitors of MBLs: Different combinations have been studied with inhibitors directed against MBLs. However, there are many obstacles to circumvent.
- MBLs possess subtle but significant variations in their active site architecture so that designing a single inhibitor efficacious against even the transferable MBLs will be problematic
- Unlike Clavulanic acid, which interacts directly with class- A enzymes and forms a stable covalent intermediate, MBLs do not form highly populated metastable reaction intermediate
- Clavulanic acid has no homologous mammalian target, i.e. it possesses relatively low toxicity. Unfortunately, MBLs have active site motifs similar to those for mammalian enzymes that are highly likely to be quintessential for cellular functions.
MBL producing bacterial isolates have been responsible for several nosocomial outbreaks in tertiary centers in different parts of the world, illustrating the need for proper infection control practices (108).In some countries, P. aeruginosa possessing MBLs constitute nearly 20% of all nosocomial isolates. These isolates have been responsible for serious infections such as septicemia and Pneumonia (109) and have been associated with failure of therapy with carbapenems.
Detection of MBLs
The catalytic mechanisms of MBLs and non MBLs are different. Therefore, different strategies are needed for the detection of pathogens harboring these enzymes in any attempt aimed at their control and eradication. Accurate identification of MBLs will therefore rely often on the availability of specific, sensitive, and simple assays able to differentiate MBLs from other Carbapenemases (146) unfortunately; there is no recommended phenotypic method available from CLSI for their detection. However, several phenotypic methods are practiced. All these methods are based on the ability of metal chelators, such as ethylene diamine tetraacetic acid (EDTA) and thiol-based compounds, to inhibit the activity of MBLs (147). These tests include
- Double disk synergy tests (DDST) using EDTA with imipenem (IPM) or ceftazidime (CAZ)
- Hodge test, a combined disk test using EDTA with CAZ or IMP.
- MBL E- test (a threefold or greater decrease in the imipenem MIC in the presence of EDTA)
- Micro dilution method using EDTA and phenanthroline with IMP
- Isoelectric focusing
- Polymerase chain reaction
The non-molecular “gold standard” is well established in research laboratories where bacterial crude cell extracts are examined for their ability to hydrolyze carbapenems and whether this hydrolysis is EDTA sensitive. These data indicate that the enzyme is being produced regardless of its genotype. However, this technique utilizes specialized spectrophotometric equipment that precludes its implementation in a routine diagnostic laboratory. Most of the current phenotypic methods described for the detection of MBLs, especially the DDST and the Hodge test, are difficult and subjective to interpret. This test can also be technically demanding and time-consuming. Besides, with these methods, MBL carrying organisms can appear susceptible to carbapenems using current CLSI or British Society for Antimicrobial Chemotherapy breakpoints. In a study over 30% of MBL carrying isolates were found to be susceptible to imipenem. Similarly, Yan et al reported that an outbreak of K. pneumoniae isolates carrying bla IMP- 8 and showed that 88% were susceptible to carbapenems. In this context, a method described by Peleg et al, 2006, seems to be effective for the phenotypic detection of carbapenem- susceptible as well as resistant MBL-producing gram-negative bacilli. They utilized several unique methodologies in an attempt to maximize the detection of such challenging organisms. They used a lower concentration of EDTA so that its bactericidal effect was minimized and they also used a lower cutoff for the increase in zone diameter with imipenem-EDTA as opposed to imipenem alone.
In brief
MBL detection method
Screening method
Antibiotics Susceptibility
Imipenem – Resistance
Meropenem – Resistance
Ceftazidime – Resistance
Confirmatory method
Put imipenem (10 µg) and combination of imipenem (10 µg) plus EDTA ( 10 µl-concentration 292µg/ml i.e. 0.1 M) disks with a distance of 25 mm from disk to disk on Muller-Hinton agar as shown above picture. After overnight incubation, ZOI of imipenem plus EDTA should be equal to and greater than 5 mm that of imipenem. The above isolate is showing the MBL producer.
Betalactamase detection|ESBL| MBL| KPC |AmpC |Oxacillinase|MRSA|D Zone test positive| iMLSB strain as shown below-
Bibliography
- Merie Queenan A, Bush K. carbapenemases: the versatile B-lactamases. Clin Microbiol Rev. 2007;20(3):440-58.
- Al-Bayssari C, Dabboussi F, Hamze M, Rolain J-M. Detection of expanded-spectrum β-lactamases in Gram-negative bacteria in the 21st century. Expert review of anti-infective therapy. 2015;13(9):1139-58.
- Wang Z, Fast W, Valentine AM, Benkovic SJ. Metallo-β-lactamase: structure and mechanism. Current opinion in chemical biology. 1999;3(5):614-22.
- Rasmussen BA, Bush K. Carbapenem-hydrolyzing beta-lactamases. Antimicrobial agents and chemotherapy. 1997;41(2):223.
- McManus-Munoz S, Crowder MW. Kinetic mechanism of Metallo-β-lactamase L1 from Stenotrophomonas maltophilia. Biochemistry. 1999;38(5):1547-53.
- Spencer J, Clarke AR, Walsh TR. Novel Mechanism of Hydrolysis of Therapeutic β-Lactams byStenotrophomonas maltophilia L1 Metallo-β-lactamase. Journal of Biological Chemistry. 2001;276(36):33638-44.
- Page MI. Understanding metallo β-lactamases. American Society for Microbiology News. 2002;68(5):217-21.
- Bellais S, Mimoz O, Léotard S, Jacolot A, Petitjean O, Nordmann P. Efficacy of β-lactams for treating experimentally induced pneumonia due to a carbapenem-hydrolyzing metallo-β-lactamase-producing strain of Pseudomonas aeruginosa. Antimicrobial agents and chemotherapy. 2002;46(6):2032-4.
- Daiyasu H, Osaka K, Ishino Y, Toh H. Expansion of the zinc metallo‐hydrolase family of the β‐lactamase fold. FEBS letters. 2001;503(1):1-6.
- Watanabe M, Iyobe S, Inoue M, Mitsuhashi S. Transferable imipenem resistance in Pseudomonas aeruginosa. Antimicrobial agents and chemotherapy. 1991;35(1):147-51.
- Peleg AY, Franklin C, Bell JM, Spelman DW. Dissemination of the metallo-β-lactamase gene blaIMP-4 among gram-negative pathogens in a clinical setting in Australia. Clinical infectious diseases. 2005;41(11):1549-56.
- Walsh TR, Toleman MA, Poirel L, Nordmann P. Metallo-β-lactamases: the quiet before the storm? Clinical microbiology reviews. 2005;18(2):306-25.
- Marchiaro P, Mussi MA, Ballerini V, Pasteran F, Viale AM, Vila AJ, et al. Sensitive EDTA-based microbiological assays for detection of metallo-β-lactamases in nonfermentative gram-negative bacteria. Journal of clinical microbiology. 2005;43(11):5648-52.
- Pitout JD, Chow BL, Gregson DB, Laupland KB, Elsayed S, Church DL. Molecular epidemiology of metallo-β-lactamase-producing Pseudomonas aeruginosa in the Calgary Health Region: emergence of VIM-2-producing isolates. Journal of clinical microbiology. 2007;45(2):294-8.
- Andrews J, Testing BWPoS. BSAC standardized disc susceptibility testing method (version 4). Journal of Antimicrobial Chemotherapy. 2005;56(1):60-76.
